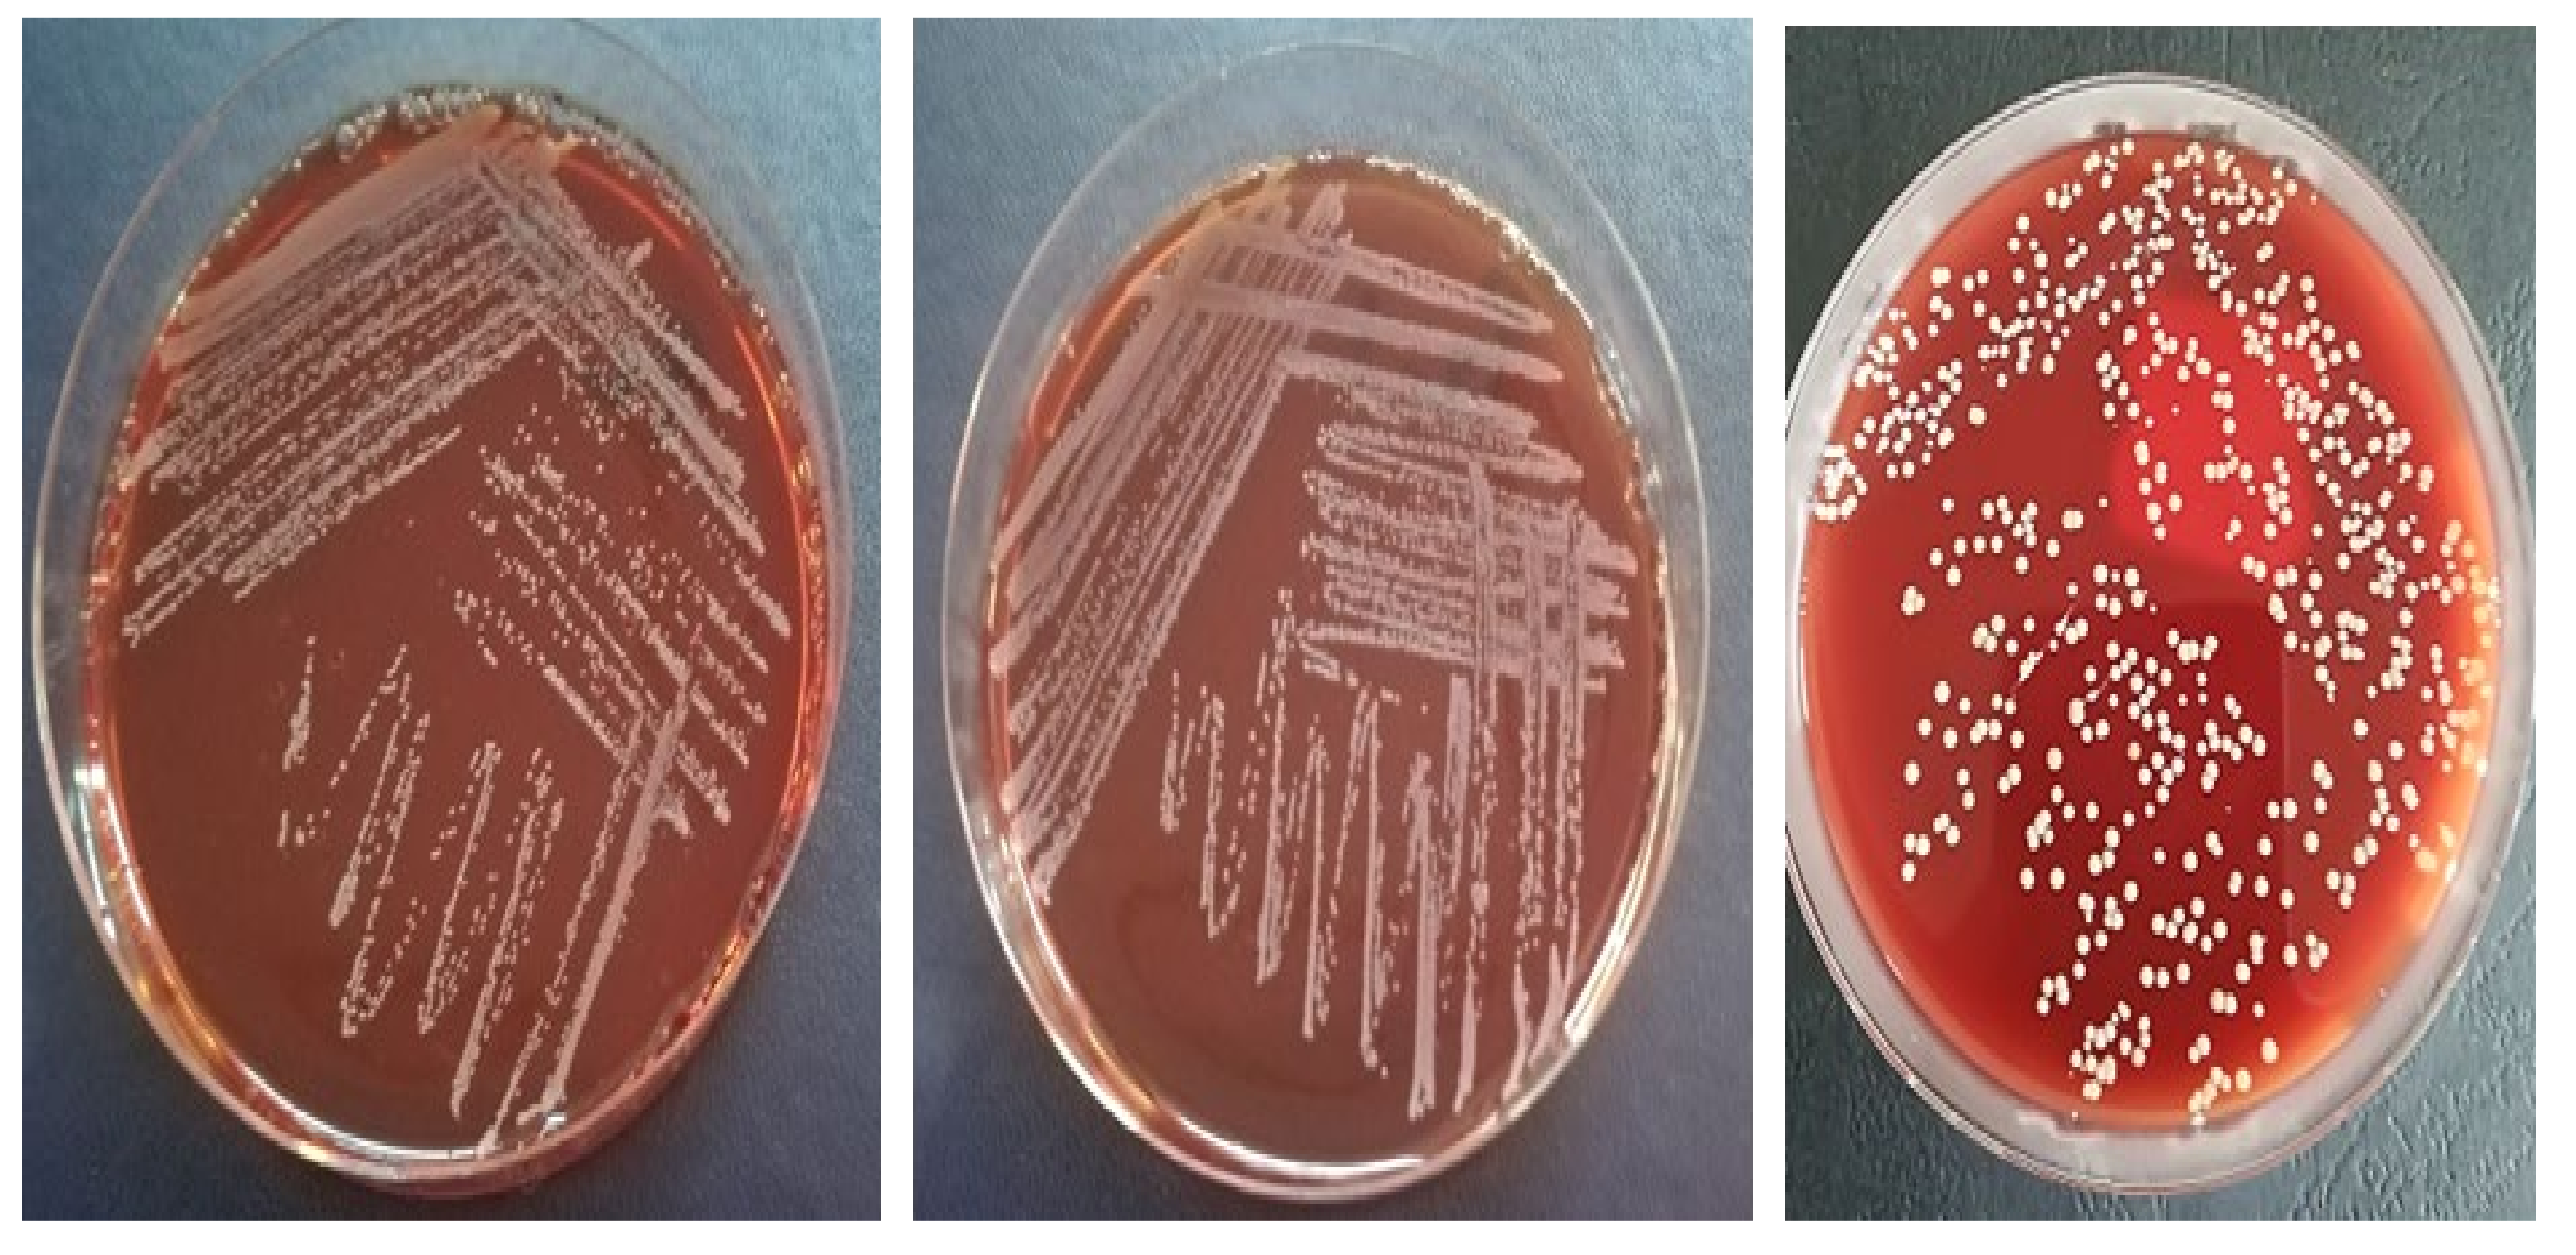
Applsci 11 09740 g001

Microcalorimetry—Versatile Method of Describing Bacterial Growth
Abstract
:Featured Application
Abstract
1. Introduction
2. Materials and Methods
2.1. Classic Method of Infections Diagnosis
2.1.1. Isolation and Identification of Bacterial Strains
2.1.2. Strain Susceptibility Testing to Antibiotics—Kirby–Bauer Disk Diffusion Susceptibility Test Protocol
2.1.3. Testing the Virulence Factors Produced by the Analyzed Strains
2.2. Bacterial Identifications Using Microcalorimetry
- We introduced in a nephelometric tube 3000 µL of sterile medium of MH; using a nephelometer, we measured the McFarland index and wrote it down.
- Using an inoculating loop, we extracted 10 µL to 20 µL of the pathological product and dispersed it in 300 µL of MH medium, ensuring that the microorganisms were homogeneously dispersed.
- Repeated pipetting of 2 µL in the nephelometric tube described in the first point until the McFarland index rose by 1.0. We pipetted only 2 µL at once to be as precise as possible.
- Sample cells were filled at room temperature and were hermetically sealed using a silicone o-ring. A batch cell containing 600 μL sterile MH was used as reference for differential scanning microcalorimetry (μDSC).
- 600 μL of the medium inoculated in point 3 were introduced in a batch cell, hermetically sealed using a silicone o-ring, and then introduced in the microcalorimeter.
- After the sample and the inoculated tubes were introduced in the cell, the acquisition program was turned on and set to maintain 37 °C temperature. We stopped and assessed the recording after the described curve went in the isothermal line for 2 up to 3 h.
3. Results
4. Discussion
5. Conclusions
Author Contributions
Funding
Institutional Review Board Statement
Informed Consent Statement
Conflicts of Interest
References
- Steiner, C.; Andrews, R.; Barrett, M.; Weiss, A. HCUP Projections: Mobility/Orthopedic Procedures 2003 to 2012. 2012. HCUP Projections Report # 2012-03. 2012 Sep 20. U.S. Agency for Healthcare Research and Quality. Available online: http://hcup-us.ahrq.gov/reports/projections/2012-03.pdf (accessed on 25 September 2021).
- Gheorghe, A.; Moran, G.; Duffy, H.; Roberts, T.; Pinkney, T.; Calvert, M. Health Utility Values Associated with Surgical Site Infection: A Systematic Review. Value Health 2015, 18, 1126–1137. [Google Scholar] [CrossRef] [Green Version]
- Li, H.K.; Rombach, I.; Zambellas, R.; Walker, S.; McNally, M.; Atkins, B.; Lipsky, B.; Hughes, H.; Bose, D.; Kumin, M. Oral versus intravenous antibiotics for bone and joint infection. N. Engl. J. Med. 2019, 380, 425–436. [Google Scholar] [CrossRef]
- Metsemakers, W.J.; Fragomen, A.T.; Moriarty, T.F.; Morgenstern, M.; Egol, K.; Zalavras, C.; Obremskey, W.; Raschke, M.; McNally, M. Evidence-based recommendations for Local antimicrobial strategies and dead space management in Fracture-Related Infection. J. Orthop. Trauma 2020, 34, 18. [Google Scholar] [CrossRef]
- Mattiassich, G.; Ortmaier, R.; Rittenschober, F.; Hochreiter, J. Diagnostic parameters in periprosthetic infections: The current state of the literature. Eur. J. Orthop. Surg. Traumatol. 2018, 28, 1573–1580. [Google Scholar] [CrossRef]
- Schwarz, E.M.; Parvizi, J.; Gehrke, T.; Aiyer, A.; Battenberg, A.; Brown, S.; Callaghan, J.; Citak, M.; Egol, K.; Garrigues, G. 2018 International Consensus Meeting on Musculoskeletal Infection: Research Priorities from the General Assembly Questions. J. Orthop. Res. 2019, 37, 997–1006. [Google Scholar] [CrossRef]
- Mauffrey, C.; Herbert, B.; Young, H.; Wilson, M.; Hake, M.; Stahel, P. The role of biofilm on orthopaedic implants: The “Holy Grail” of post-traumatic infection management. Eur. J. Trauma Emerg. Surg. 2016, 42, 411–416. [Google Scholar] [CrossRef] [PubMed]
- Mihailescu, R.; Furustrand Tafin, U.; Corvec, C.; Olivia, A.; Betrisey, B.; Borens, O.; Trampuz, A. High Activity of Fosfomycin and Rifampin against Methicillin-Resistant Staphylococcus aureus Biofilm In Vitro and in an Experimental Foreign-Body Infection Model. Antimicrob Agents Chemother. 2014, 58, 2547–2553. [Google Scholar] [CrossRef] [PubMed] [Green Version]
- Govaert, G.A.M.; Kuehl, R.; Trampuz, A.; Atkins, B.; Morgenstern, M.; Obremskey, W.; Verhofstad, M.; McNally, M.; Metsemakers, W. Diagnosing Fracture-related infection: Current concepts and recommendations. J. Orthop. Trauma 2020, 34, 8. [Google Scholar] [CrossRef] [PubMed]
- Conlan, T.; Beebe, M.; Weinlei, C. New Imaging, Diagnostic and Assessment Techniques in Orthopedic Trauma. Orthop. Clin. N. Am. 2019, 50, 47–56. [Google Scholar] [CrossRef] [PubMed]
- Mihai, M.M.; Holban, A.M.; Giurcaneanu, C.; Popa, L.G.; Oanea, R.M.; Lazar, V.; Chifiriuc, M.C.; Popa, M.; Popa, M.I. Microbial biofilms: Impact on the pathogenesis of periodontitis, cystic fibrosis, chronic wounds and medical device-related infections. Curr. Top. Med. Chem. 2015, 15, 1552–1576. [Google Scholar] [CrossRef]
- Parvizi, J.; Zmistowski, B.; Berbari, E.; Bauer, T.W.; Springer, B.D.; Della, C.J.; Garvin, K.L.; Mont, M.A.; Wongworwawat, M.D.; Zalavras, C.G. New definition for periprosthetic joint infection: From the workgroup of the Musculoskeletal Infection Society. Clin. Orthop. Relat. Res. 2011, 469, 2992–2994. [Google Scholar] [CrossRef] [PubMed] [Green Version]
- Zaharia, D.C.; Popa, M.G.; Steriade, A.T.; Muntean, A.A.; Balint, O.; Micuţ, R.; Popa, V.T.; Popa, M.I.; Bogdan, M.A. Microcalorimetry—A new method for bacterial characterisation. Pneumologia 2013, 62, 232–235. [Google Scholar] [PubMed]
- Renard, G.; Laffosse, J.; Tibbo, M.; Luceana, T.; Cavaignac, E.; Rouvillain, J.L.; Chiron, P.; Severyns, M.; Reina, N. Periprosthetic joint infection in aseptic total hip arthroplasty revision. Int. Orthop. 2019, 44, 735–741. [Google Scholar] [CrossRef] [PubMed]
- Cursaru, A.; Cretu, B.; Serban, B.; Lupu, A.G.; Iacobescu, G.; Popa, M.; Cursaru, R.; Cirstoiu, C. Mechanical Safety Study and Antibiotic-loaded Polumethylmethacrylate Spacers Threshold, Manufactured Intraoperatively, in orthopaedic Surgery. Mater. Plast. 2020, 57, 317–324. [Google Scholar] [CrossRef]
- Rak, M.; Kavcic, M.; Trebse, R.; Cor, A. Detection of bacteria with molecular methods in prosthetic joint infection: Sonication fluid better than periprosthetic tissue. Acta Orthop. 2016, 87, 339–345. [Google Scholar] [CrossRef] [PubMed] [Green Version]
- James, A.M. Thermal and energetic studies of cellular biological systems. Bristol. Wright. 1987, 1, 5–67 ISBN: 9781483193557. [Google Scholar]
- Tellapragada, C.; Hasan, B.; Antonelli, A.; Maruri, A.; Vogel, C.; Gijon, D.; Coppi, M.; Verbon, A.; Wamel, W.; Rossolini, G.M.; et al. Isothermal microcalorimetry minimal inhibitory concentration testing in extensively drug resistant Gram-negative bacilli: A multicentre study. Clin. Microbiol. Infect. 2020, 26, 1413.e1–1413.e7. [Google Scholar] [CrossRef] [Green Version]
- Beezer, A.E.; Bettelheim, K.; Newell, R.D.; Stevens, J. Diagnosis of bacteriuria by flow microcalorimetry: Preliminary report. Sci. Tools 1974, 21, 13–16. [Google Scholar]
- Maskow, T.; Wolf, K.; Kunze, W.; Enders, S.; Harms, H. Rapid analysis of bacterial contamination of tap water using isothermal calorimetry. Thermochim. Acta 2012, 543, 273–280. [Google Scholar] [CrossRef]
- Wadsö, I. Isothermal microcalorimetry in applied biology. Thermochim. Acta 2002, 394, 305–311. [Google Scholar] [CrossRef]
- Braissant, O.; Keiser, J.; Meister, I.; Bachmann, A.; Wirz, D.; Gopfert, B.; Bonkat, G.; Wadso, I. Isothermal microcalorimetry accurately detects bacteria, tumorous microtissues, and parasitic worms in a label-free well-plate assay. Biotechnol. J. 2015, 10, 460–468. [Google Scholar] [CrossRef] [Green Version]
- Braissant, O.; Muller, G.; Egli, A.; Widmer, A.; Frei, R.; Halla, A.; Wirz, D.; Gasser, T.C.; Bachmann, A.; Wagenlehner, F.; et al. Seven hours to adequate antimicrobial therapy in urosepsis using isothermal microcalorimetry. J. Clin. Microbiol. 2014, 52, 624–626. [Google Scholar] [CrossRef] [Green Version]
- Borens, O.; Yusuf, E.; Steinrucken, J.; Trampuz, A. Accurate and early diagnosis of orthopedic device-related infection by microbial heat production and sonication. J. Orthop. Res. 2013, 31, 1700–1703. [Google Scholar] [CrossRef]
- Zaharia, D.C.; Iancu, C.; Steriade, A.T.; Muntean, A.A.; Balint, O.; Popa, V.T.; Popa, M.I.; Bogdan, M.A. MicroDSC study of Staphylococcus epidermidis growth. BMC Microbiol. 2010, 10, 322. [Google Scholar] [CrossRef] [Green Version]
- Keiser, J.; Manneck, T.; Kirchhofer, C.; Braissant, O. Isothermal microcalorimetry to study the activity of triclabendazole and its metabolites on juvenile and adult Fasciola hepatica. Exp. Parasitol. 2013, 133, 265–268. [Google Scholar] [CrossRef]
- Marmor, S.; Kerroumi, Y. Patient-specific risk factors for infection in arthroplasty procedure. Orthop. Traumatol. Surg. Res. 2016, 102 (Suppl. 1), S113–S119. [Google Scholar] [CrossRef]
- Popa, M.G.; Popa, V.; Muntean, A.A.; Popa, V.T.; Dragomirescu, C.C.; Eremia, I.; Nica, S.; Popa, M.I.; Cîrstoiu, C. Microcalorimetric growth evaluation of Candida albicans in different condition. Situations 2020, 7, 9. [Google Scholar] [CrossRef]
- Graves, N.; Wloch, C.; Wilson, J.; Wilson, J.; Barnett, A.; Sutton, A.; Cooper, N.; Merollini, K.; McCreanor, V.; Cheng, Q.; et al. A cost-effectiveness modelling study of strategies to reduce risk of infection following primary hip replacement based on a systematic review. Health Technol. Assess. 2016, 20, 1–144. [Google Scholar] [CrossRef] [Green Version]
- Butini, M.E.; Abbandonato, G.; Trampuz, A.; Rienzo, C.D.; Di Luca, M. Isothermal microcalorimetry detects the presence of persister cells in a Staphylococcus aureus biofilm after vancomycin treatment. Front. Microbiol. 2019, 10, 332. [Google Scholar] [CrossRef]
- Xie, C.L.; Wang, H.; Qu, S.S. Microcalorimetric study on the aerobic growth of Escherichia coli. Thermochim. Acta 1995, 253, 175–182. [Google Scholar] [CrossRef]
- Kabanova, N.; Kazarjan, A.; Stulova, I.; Vilu, R. Microcalorimetric study of growth of Lactococcus lactis IL1403 at different glucose concentrations in broth. Thermochim. Acta 2009, 496, 87–92. [Google Scholar] [CrossRef]
- Song, Z.; Borgwardt, L.; Hoiby, N.; Wu, H.; Sorensen, T.S.; Borgwardt, A. Prosthesis infections after orthopedic joint replacement: The possible role of bacterial biofilms. Orthop. Rev. 2013, 5, 65–71. [Google Scholar] [CrossRef] [Green Version]
- Romano, C.L.; Trentinaglia, M.T.; De Vecchi, E.; Logoluso, N.; George, D.A.; Morelli, I.; Drago, L. Cost-beneft analysis of antibiofilm microbiological techniques for peri-prosthetic joint infection diagnosis. BMC Infect Dis. 2018, 18, 154. [Google Scholar] [CrossRef] [Green Version]
- Renz, N.; Yermak, K.; Perka, C.; Trampuz, A. Alpha defensin lateral flow test for diagnosis of periprosthetic joint infection. Not a screening but a confirmatory test. J. Bone Jt. Surg. Am. 2018, 100, 742–750. [Google Scholar] [CrossRef]
- Saleh, A.; Guirguis, A.; Klika, A.; Johnson, L.; Higuera, C.A.; Barsoum, W.K. Unexpected positive intraoperative cultures in aseptic revision arthroplasty. J. Arthroplast. 2014, 29, 2181–2186. [Google Scholar] [CrossRef]
- Berend, K.R.; Lombardi, A.V.; Adams, J.B. Unexpected positive intraoperative cultures and gram stain in revision total hip arthroplasty for presumed aseptic failure. Orthopedics 2014, 30, 1051–1053. [Google Scholar] [CrossRef]
- Wee, A.T.; Morrey, B.F.; Sanchez-Sotelo, J. The fate of elbows with unexpected positive intraoperative cultures during revision elbow arthroplasty. J. Bone Joint. Surg. Am. 2013, 95, 109–116. [Google Scholar] [CrossRef]
- Barrack, R.; Aggarwal, A.; Burnett, R.; Clohisy, C.J.; Ghanem, E.; Sharkey, P.; Parvizi, J. The fate of the unexpected positive International Orthopaedics (SICOT) intraoperative cultures after revision total knee arthroplasty. J. Arthroplast. 2007, 22, 94–99. [Google Scholar] [CrossRef] [Green Version]
- Morgenstern, C.; Cabric, S.; Perka, C.; Trampuz, A.; Renz, N. Synovial fluid multiplex PCR is superior to culture for detection of low-virulent pathogens causing periprosthetic joint infections. Diagn. Microbiol. Inf. Dis. 2018, 90, 115–119. [Google Scholar] [CrossRef]
- Suda, A.; Tinelli, M.; Beisemann, N.; Weil, Y.; Khoury, A.; Bischel, O.E. Diagnosis of periprosthetic joint infection using alpha-defenin test of multiple-PCR: Ideal diagnostic test still not found. Int. Orthop. 2017, 41, 1307–1313. [Google Scholar] [CrossRef]
- Calvet, E.; Prat, H. Recent Progress in Microcalorimetry; Macmillan Peergamon Press: Oxford, UK, 1963; pp. 12–45. ISBN 9781483280134. [Google Scholar]
- Muntean, A.A.; Zaharia, D.C.; Balint, O.; Steriade, A.T.; Popa Mihnea, G.I.; Tofolean, I. Microcalorimetry for bacterial strain discrimination—A first step in developing a novel technique for the diagnosis of severe infections. Eur. Respr. J. 2013, 42 (Suppl. 57), P2768. [Google Scholar]
- Popa, M.I.; Cursaru, A.; Popa, V.; Muntean, A.; Bogdan, S.; Cretu, B.; Iordache, S.; Cirstoiu, C. Study of bacterial proliferation using a method that shows bacterial growth depending on the heat released–microcalorimetry. Proc. Rom. Acad. Ser. B 2021, 23, 197–203. [Google Scholar]
- Popa, M.; Ene, R.; Streinu, C.; Popa, V.; Pleniceanu, M.; Nica, M.; Panti, Z.; Cirstoiu, M.; Cîrstoiu, M.; Cîrstoiu, C. Algic syndrome in osteoarticular infectious pathology; detection and rapid treatment of the causative agent using microcalorimetry. In Proceedings of the 14th National Congress of Urogynecology and the National Conference of the Romanian Association for the Study of Pain, Eforie, Romania, 17–19 September 2017; pp. 589–594, ISSN 978-88-95922-98-0. [Google Scholar]
- Alklint, C.; Wadsö, L.; Sjöholm, I. Accelerated storage and isothermal microcalorimetry as methods of predicting carrot juice shelf-life. J. Sci. Food Agric. 2005, 85, 281–285. [Google Scholar] [CrossRef]
- Popa, M.; Serban, B.; Popa, V.T.; Nedelcu, R.; Cursaru, A.; Cîrstoiu, C. Utility of microcalorimetru in describing the growth curve of Candida albicans at different temperatures–identitying the optimal growth temperature. Rom. J. Orthop. Surg. Traumatol. 2019, 2, 69–74. [Google Scholar]
- Di Luca, M.; Koliszak, A.; Karbysheva, S.; Chowdhary, A.; Meis, J.F.; Trampuz, A. Thermogenic characterization and antifungal susceptibility of Candida auris by microcalorimetry. J. Fungi 2019, 5, 103. [Google Scholar] [CrossRef] [PubMed] [Green Version]
- Corvec, S.; Wang, L.; Trampuz, A.; Seiler, E.; Moreno, M.G. Characterization of medical relevant anaerobic microorganisms by isothermal microcalorimetry. Anaerobe 2020, 66, 102282. [Google Scholar] [CrossRef] [PubMed]
- Zaharia, D.; Muntean, A.; Popa, M.G.; Steriade, A.; Balint, O.; Micut, R.; Iftene, C.; Tofolean, I.; Popa, V.T.; Baicus, C.; et al. Comparative analysis of Staphylococcus aureus and Escherichia coli microcalorimetric growth. BMC Microbiol. 2013, 13, 171. [Google Scholar] [CrossRef] [Green Version]

| Bacteria | P | FOX | CPT | CIP | STX | RIF | CN | AZM | E | DA | TE | LZD |
|---|---|---|---|---|---|---|---|---|---|---|---|---|
| S. epidermidis | R | R | R | S | S | S | S | R | R | S | R | S |
| S. aureus | R | S | R | S | S | S | S | S | S | S | S | S |
| S. aureus | R | S | R | S | S | S | S | S | S | S | S | S |
Publisher’s Note: MDPI stays neutral with regard to jurisdictional claims in published maps and institutional affiliations. |
© 2021 by the authors. Licensee MDPI, Basel, Switzerland. This article is an open access article distributed under the terms and conditions of the Creative Commons Attribution (CC BY) license (https://creativecommons.org/licenses/by/4.0/).
Share and Cite
Popa, M.I.G.; Cursaru, A.; Serban, B.; Cretu, B.; Muntean, A.A.; Popa, V.T.; Chifiriuc, M.C.; Cîrstoiu, C. Microcalorimetry—Versatile Method of Describing Bacterial Growth. Appl. Sci. 2021, 11, 9740. https://doi.org/10.3390/app11209740
Popa MIG, Cursaru A, Serban B, Cretu B, Muntean AA, Popa VT, Chifiriuc MC, Cîrstoiu C. Microcalorimetry—Versatile Method of Describing Bacterial Growth. Applied Sciences. 2021; 11(20):9740. https://doi.org/10.3390/app11209740
Chicago/Turabian StylePopa, Mihnea Ioan Gabriel, Adrian Cursaru, Bogdan Serban, Bogdan Cretu, Andrei Alexandru Muntean, Vlad Tudor Popa, Mariana Carmen Chifiriuc, and Cătălin Cîrstoiu. 2021. "Microcalorimetry—Versatile Method of Describing Bacterial Growth" Applied Sciences 11, no. 20: 9740. https://doi.org/10.3390/app11209740
APA StylePopa, M. I. G., Cursaru, A., Serban, B., Cretu, B., Muntean, A. A., Popa, V. T., Chifiriuc, M. C., & Cîrstoiu, C. (2021). Microcalorimetry—Versatile Method of Describing Bacterial Growth. Applied Sciences, 11(20), 9740. https://doi.org/10.3390/app11209740

